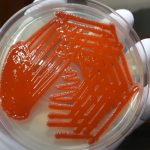
S. marcescens: Introduction, Classification, Pathogenecityl, Lab Diagnosis, Treatment, Prevention and Keynotes

Tag: S. marcescens
S. marcescens: Introduction, Classification, Pathogenecityl, Lab Diagnosis, Treatment, Prevention and Keynotes
 Introduction of S. marcescens Serratia is a genus of Gram-negative,...
Introduction of S. marcescens Serratia is a genus of Gram-negative,...
Introduction of S. marcescens Serratia is a genus of Gram-negative,...
Introduction of S. marcescens Serratia is a genus of Gram-negative,...